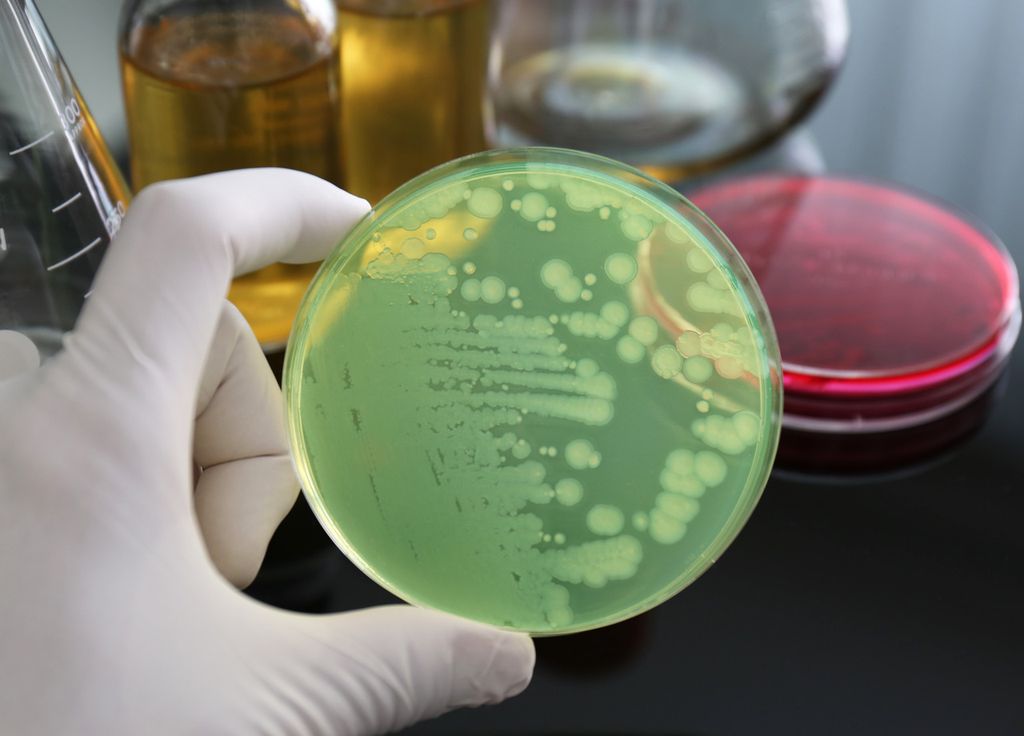
Cancer Bactérie Estomac

Nés entre 2008 et 2017 : vous avez plus de risques de développer un cancer de l'estomac. Découvrez pourquoi !
La bactérie Helicobacter pylori est un pathogène présent dans l'estomac d'une personne sur 2. Sauf qu'elle peut causer de graves problèmes gastriques pouvant aller jusqu'au cancer de l'estomac.
Au total, 15,6 millions de personnes sont nées entre 2008 et 2017. Autant de personnes donc susceptibles de développer un cancer de l'estomac dans les années à venir à cause de la bactérie "Helicobacter pilori", selon une étude publiée le 7 juillet dernier dans le revue scientifique Nature Medicine.
Cette bactérie est un pathogène qui s'attrape par la salive "essentiellement dans les cinq premières années de vie", révèle la Haute Autorité de Santé (HAS). Et persiste toute la vie. Helicobacter pylori est déjà présente dans l'estomac d'une partie de la population. Sauf qu'elle pourrait avoir des conséquences mortelles. Heureusement, un traitement existe.
️ 12 millions de cancers évitables ?
Charbellakis (@charbofficiel) July 21, 2025
Cest ce que révèle une étude publiée dans Nature Medicine : une simple bactérie, Helicobacter pylori, pourrait provoquer près de 80 % des cancers de lestomac dans les années à venir.
Présente chez près d1 personne sur 2 dans le monde, pic.twitter.com/XNyjEIyixH
Lorsqu'une personne est contaminée par la bactérie, elle risque de souffrir d'inflammation chronique de la muqueuse de l'estomac et d'engendrer des problèmes gastriques comme l'ulcère. 90% des cancers de l'estomac sont associés à cette bactérie. Qui est l'infection bactérienne chronique la plus répandue dans le monde.
Sur toutes les personnes atteintes par la bactérie, seuls 1% développeront un cancer de l'estomac en raison de différents facteurs cumulés : la génétique, l'alimentation ou encore l'environnement. Helicobacter pylori est prise au sérieux dans de nombreux pays d'Asie (qui concentre les 2 tiers des cas attendus). Suivi de l'Amérique et de l'Afrique.
En Europe, les scientifiques auteurs de l'étude estiment que l'incidence pourrait s'élever à 900 800 cas parmi toutes les personnes nées entre 2008 et 2017. En France, environ 30% de la population serait porteuse de Helicobacter pylori. Mais le gouvernement n'a, pour l'instant, rien prévu pour dépister et traiter les personnes infectées.
Tandis que le Japon propose d'ores et déjà des actions de dépistage pour les personnes de 40 ans et plus. Car les régions de l'est de l'Asie (Chine et Japon) la bactérie est beaucoup plus agressive. Mais l'Afrique subsaharienne (peu touchée par les cancers gastriques) va peut-être voir le nombre de cas multiplier par 6 d'ici 2100. Un dépistage prématuré et une prise en charge rapide permettraient d'éviter les 3 quarts des cancers à venir !
Helicobacter pylori est une bactérie qui colonise l'estomac et est souvent associée à diverses affections gastriques, notamment la gastrite, les ulcères gastriques et duodénaux, et elle est également un facteur de risque pour le cancer de l'estomac. Les symptômes pic.twitter.com/cHvk4FkUsT
Reine des prés (@pres_reine) March 15, 2025
"Il est essentiel que les autorités sanitaires fassent de la prévention du cancer gastrique une priorité, et accélèrent les efforts pour le contrôler en planifiant des projets pilotes, y compris des programmes de dépistage et de traitement de Helicobacter pylori", explique le Dr Jin Young Park, co-auteur de l’étude.
D'autant que cette infection bactérienne peut être traitée facilement, en traitant la bacille. Le traitement consiste à associer des antibiotiques et un inhibiteur durant environ 15 jours. Dans 80 à 90% des cas, la bactérie est éliminée. Le cancer est l’une des principales causes de mortalité dans le monde avec 10 millions de décès en 2020, d'après les données de l'OMS.
Après le cancer du poumon, le cancer colorectal, le cancer du foie, le cancer de l'estomac est le 4ème cancer le plus mortel au monde. Devant le cancer du sein. Alors que ce cancer gastrique peut être éviter grâce à la prévention et au dépistage.
Références de l'article :
Julie Bernichan, LeParisien, (17/07/2025), « Helicobacter pylori » : c’est quoi cette bactérie qui pourrait causer des millions de cancers de l’estomac dans les décennies à venir ?
Park, J.Y., Georges, D., Alberts, C.J. et al. Estimations mondiales de la durée de vie des cancers gastriques attendus et évitables dans 185 pays. Nat Med (2025).